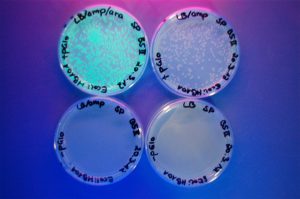

Unsere Schule
individuelle Betreuung
öffentlich gut erreichbar
direkt an der Isar
staatlich anerkannte Abschlüsse
BAföG-tauglich
Schwerpunkt Wahl
Finanzierung
Alle Informationen zu Kosten und Tipps für die Finanzierung findest du auf unserer Finanzierungsseite.
Für Schüler/innen
Hier findest du alle relevanten Informationen rund um deine Aus-/Fortbildung bei uns.
Beispielsweise Stundenpläne, verschiedene Hilfsangebote, sowie die Termine zu unseren Schulfeiern!
Nach der Ausbildung
Für unsere Absolventen bieten wir exklusive Stellenangebote und helfen individuell bei der Job-Suche.